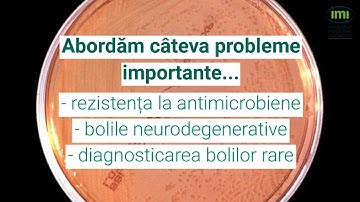
Launch of the last IMI2 Calls for proposals - Romanian
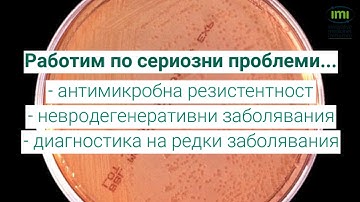
Launch of the last IMI2 Calls for proposals - Bulgarian

⬇ DOWNLOAD NOW
Kalau muncul iklan pop-up, tutup lalu klik tombol kembali
Download lagu Launch of the last IMI2 Calls for proposals EN secara gratis hanya untuk keperluan promosi. Dukung artis favorit kamu dengan membeli musik original di iTunes atau platform resmi lainnya.
Launch of the last IMI2 Calls for proposals - Romanian
Launch of the last IMI2 Calls for proposals - Romanian
Launch of the last IMI2 Calls for proposals - Bulgarian
Launch of the last IMI2 Calls for proposals - Bulgarian
 Launch of the last IMI2 Calls for proposals - Czech
Launch of the last IMI2 Calls for proposals - Czech
 Webinar: Rules and Procedures for IMI2 Calls for proposals
Webinar: Rules and Procedures for IMI2 Calls for proposals
 WALD Innovation Facility: Call for Proposals, Information Session 1
WALD Innovation Facility: Call for Proposals, Information Session 1
 IMI2 - Call 20: updated draft topics (Dec. 2019)
IMI2 - Call 20: updated draft topics (Dec. 2019)
 Q&A Webinar | IPA Consumer Protection Call for Proposals | April 16, 2025
Q&A Webinar | IPA Consumer Protection Call for Proposals | April 16, 2025
 Questions & Answers: Rules and Procedures for IMI2 Calls for proposals
Questions & Answers: Rules and Procedures for IMI2 Calls for proposals